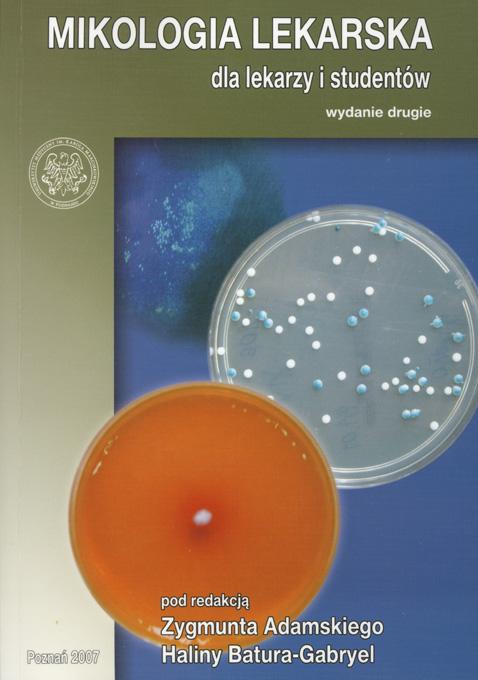
Mikologia Lekarska dla lekarzy i studentów

Nakład wyczerpany
Mikologia Lekarska dla lekarzy i studentów
Z przedmowy do wydania drugiego
Z prawdziwą przyjemnością przygotowaliśmy drugie wydanie Mikologii lekarskiej dla lekarzy i studentów. Zobligowało nas do tego duże zainteresowanie wydaną w 2005 roku pierwszą wersją podręcznika. Jest szczególnie ważne dla autorów, że książka spełniła swoje zadanie - zwróciła uwagę na zagrożenia, jakie stanowią grzybice u ludzi i zwierząt i pomogła w podjęciu bardziej racjonalnych działań, mających na celu zwalczanie tych zakażeń.
Wydanie drugie jest rozszerzone i uzupełnione o nowe informacje, tak aby książka mogła być przydatna w różnych sytuacjach medycznych, ponieważ rozprzestrzenianie się grzybic stanowi narastający i coraz poważniejszy problem dla wielu lekarzy.
(...) Książkę tę dedykujemy naszym współpracownikom w Katedrze Ftyzjopneumonolgii oraz w Zakładzie Mikologii Lekarskiej i Dermatologii Uniwersytetu Medycznego w Poznaniu i Oddziale Chorób Skóry Szpitala Wojewódzkiego w Poznaniu.
Zygmunt Adamski, Halina Batura-Gabryel